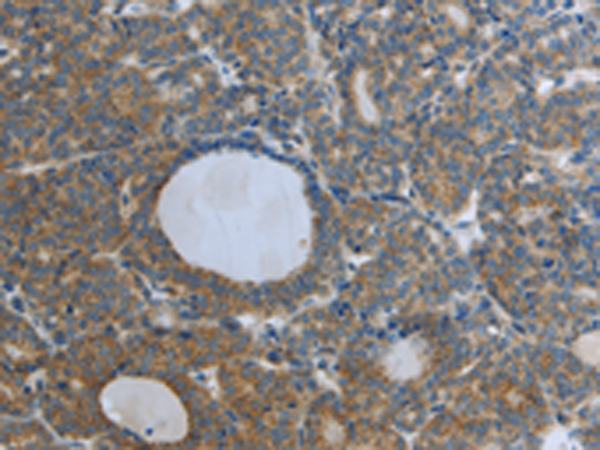
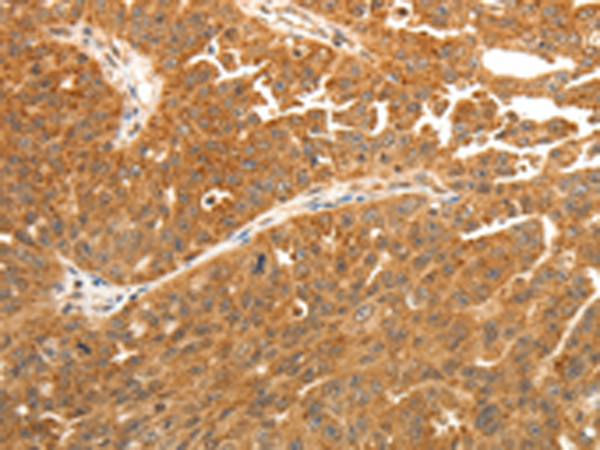

-
分类: 科研抗体货号: P00677别名: SemE; SEMAE应用: WB,IHC反应种属: Human, Mouse
-
分类: 科研抗体货号: P00668别名: ADSF, RSTN, XCP1, FIZZ3, RETN1应用: IHC反应种属: Human
-
分类: 科研抗体货号: P00733别名: TF; TFA; CD142应用: WB,IHC反应种属: Human
-
分类: 科研抗体货号: P00666别名: RAR; NR1B1应用: IHC反应种属: Human, Mouse
-
分类: 科研抗体货号: P00769别名: HASH; SRF1; SRF-1应用: IHC反应种属: Human, Mouse, Rat
-
分类: 科研抗体货号: P00732别名: pS2; BCEI; HPS2; HP1.A; pNR-2; D21S21应用: WB反应种属: Human
-
分类: 科研抗体货号: P00654别名: P40, S12, Rpn8, MOV34应用: IHC反应种属: Human, Mouse
-
分类: 科研抗体货号: P00767别名: TRP7应用: IHC反应种属: Human, Mouse
-
分类: 科研抗体货号: P00731别名: SP; SML1应用: IHC反应种属: Human, Mouse, Rat
-
分类: 科研抗体货号: P00650别名: CLA; CD162; PSGL1; PSGL-1应用: IHC反应种属: Human

鄂公网安备42018502007531号
鄂公网安备42018502007531号

